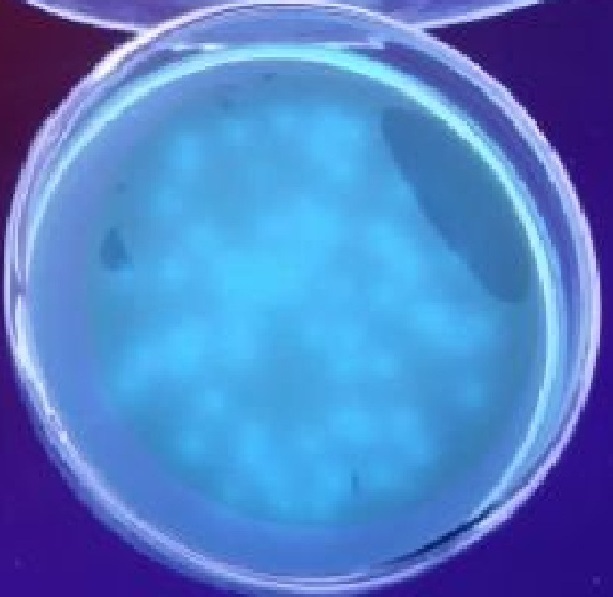

医学伦理学
曹永福 山东大学 报名数量:0
课程简介: 医学医术与伦理道德如影随形,须臾不可分离。医学伦理学研究医学中的道德和伦理问题。医学生需要接受医学伦理教育:需要把握有关医学道德知识、训练伦理思维能力、提升医学职业素养。课程以...

内科学
南阳理工学院李忠等 报名数量:0
课程简介: 希波克拉底说:医术是一切技术中最美和最高尚的。医学是什么?对于医学生来说,选择医学可能是偶然,但一旦选择了,就必须用一生的忠诚和热情去对待它。对于普通大众来说,医学是遥不可及的...
卫生微生物学
刘艳超 内蒙古医科大学 报名数量:0
课程简介: 卫生微生物学课程主要介绍了绪论、微生物与环境、卫生微生物学检验特点及基本原则、卫生微生物学检验方法、消毒与灭菌、微生物实验室生物安全及生物战剂防护、水微生物、土壤微生物、空气微...

实验针灸学
佘延芬 河北中医学院 报名数量:0
课程简介: 该课程主要介绍针灸学中经络腧穴理论、刺灸法效应、针灸作用原理、针灸作用效应规律等一系列问题的研究思路、研究结果、研究现状、取得的研究成果以及研究的发展历程等内容,揭示针灸预防和...


